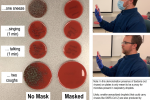

شش ماه پس از همهگیری کووید-۱۹ که منجر به مرگ نیم میلیون انسان شده، بیش از ۲۰۰ دانشمند از سراسر جهان دیدگاه رسمی درباره ویروس کرونا را به چالش کشیده و تاکید کردند که هشدارهای سازمان جهانی بهداشت و مرکز کنترل بیماریهای آمریکا کافی نیست.
انتقاد این دانشمندان به هشدارهای سازمان جهانی بهداشت و مرکز کنترل بیماریهای آمریکا بازمیگردد که میگوید مردم باید تنها در خصوص دو نوع انتقال نگران باشند: ذرات تنفسی که از یک فرد آلوده به ویروس در فاصله نزدیک در هوا منتشر شده و یا موردی که کمتر معمول است، لمس یک سطح آلوده و سپس لمس چشمها، بینی یا دهان.
Read More
This section contains relevant reference points, placed in (Inner related node field)
اما کارشناسان معتقدند که یک راه سوم هم برای انتقال ویروس وجود دارد که نقش مهمی در ابتلای افراد به ویروس کرونا داشته اما در دستورالعملها نادیده گرفته شدهاست.
به گزارش لسآنجلس تایمز، دانشمندان به مطالعات متعدد استناد میکنند که نشان داده است ذراتی میکروسکوپی همراه با تنفس عادی در هوا پخش میشوند و میتوانند برای مدتهای طولانی در هوا معلق بمانند و به فاصله دهها متر با جریان هوا جابهجا شوند.
به همین دلیل، اتاقهایی که تهویه نامناسب دارند، اتوبوسها و دیگر اماکن بسته، حتی وقتی افراد به اندازه حدود ۲ متر از یکدیگر فاصله میگیرند، خطرناک هستند.
لیدیا موراوسکا، پروفسور علوم اتمسفری و مهندسی محیطی دانشگاه فناوری کویینزلند در بریستول استرالیا میگوید: «ما صد در صد از این موضوع اطمینان نداریم.»
او این موضوع را در نامه سرگشادهای با سازمان جهانی بهداشت درمیان گذاشته و نهادهای سازمان مللمتحد را به شکست در صدور هشدارهای مناسب درباره خطرات این ویروس متهم کردهاست. ۲۳۹ پژوهشگر از ۳۲ کشور این نامه را امضا کردهاند و هفته آینده در یک مجله علمی منتشر خواهد شد.
کارشناسان در مصاحبههای متعدد گفتهاند که بهنظر میرسد این راه سوم انتقال ویروس، تنها راه توضیح انتشار بسیار وسیع آن در مراسمی باشد که حتی افراد با رعایت فاصله شرکت میکنند.
مقامهای سازمان جهانی بهداشت تایید کردهاند که ویروس کرونا از طریق انتشار در هوا منتشر میشود، اما گفتهاند که این در مواردی همچون محیط آزمایشگاه که مقدار زیادی ویروس در یک لوله ریخته میشود، اتفاق میافتد. دکتر بندتا الگرانزی، یک مقام ارشد سازمان جهانی بهداشت در امور پیشگیری و کنترل عفونت، در پاسخ به سوالی که در این خصوص از سوی نشریه تایمز مطرح شده گفته است: تئوریهایی موراوسکا و گروهش بیشتر بر اساس تجربیات آزمایشگاهی مطرح شده تا اینکه شواهد میدانی داشتهباشد.